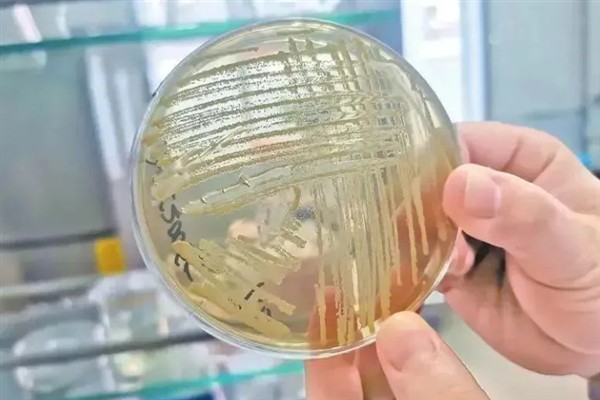
光合菌在水产养殖中有何作用,能起到改良水质、预防疾病等效果

在水产养殖中合理使用光合菌,有改良水质、预防疾病等作用,而且还能作为饲料给刚孵化出的鱼苗食用。
使用前,需混合光合菌与精细肥泥,于晴天且水温高于20℃以上时,均匀的撒入池内,在后期,需每隔20天,喷洒光合菌兑水后的混合液1次,促进藻类生长,给鱼类提供食物与良好的栖息环境。
光合菌属于有益微生物,不仅能降解水体中的残存饵料、粪便等东西,还能抑制有害病菌的生长繁殖。

一、光合菌在水产养殖中有何作用
1、使用时间
鱼塘使用前,需要用光合菌混合精细肥泥均匀撒入池内,促进藻类生长,为鱼类提供食物和栖息环境,并且后期要每隔20天喷洒一次光合菌兑水后的混合液,而且需要注意的是光合菌最好在晴天且水温高于20度以上时进行。
2、改良水质
光合菌可以降解水体中的残存饵料、粪便等物资,将光合菌泼洒在鱼塘中后,它可以吸收水体中的氨气、亚硝酸盐、硫化氢等有害物质,促进有机物循环,起到改良水质的作用。

3、作为饲料
光合菌具有较高的营养价值,含有丰富粗蛋白质、粗脂肪、可溶性糖类和必需氨基酸,能够为鱼类提供饲料,并且光合菌的菌体较为微小,仅为小球藻的二十分之一,适合刚孵化出来的鱼苗食用。

4、预防疾病
光合菌是有益微生物,能抑制有害病菌的生长和繁殖,降低了有害病菌数量,并且在鱼塘里面泼洒光合菌时,可以抑制蓝藻等有害藻类生长,使得硅藻、小球藻等适宜鱼类食用的藻类旺盛生长。

二、em菌在水产养殖中的作用
1、增强水产物的抵抗力
(1)在水产物的饲料中合理的添加EM菌,利于水产物肠道中有益菌的生长繁殖,使得水产物可以更好的消化和吸收营养物质。

(2)同时em菌还能够激活免疫系统,从而增强水产物的抗病能力。

2、调节水质
(1)当em菌进入水体之后,便会快速生长繁殖并形成有益菌优势种群,而有益菌又可以分解掉水产物的代谢物以及食物残渣,从而降低水体中有毒物质的浓度。

(2)而且当水体中的有机物被分解之后,还可以为浮游植物提供生长所需的营养物质,使得浮游植物能够更好进行光合作用,随后便会为水产物提供大量的氧气并形成一个良好的循环,使得水体呈“活、肥、爽、嫩”的状态,为水产物提供一个良好的生长环境。




